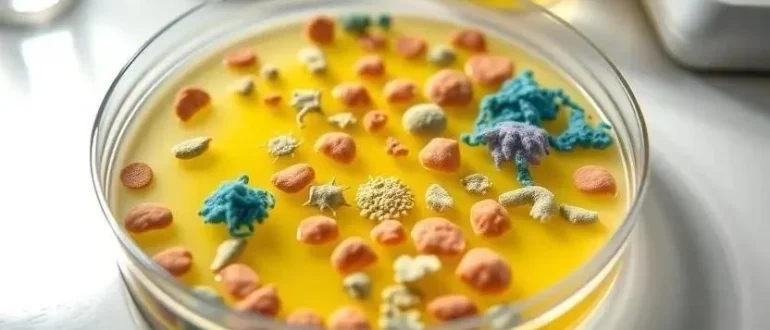

Болезни растений
Узнайте, как санитарно-эпидемиологический контроль оберегает нас от болезней! Важная статистика, принципы работы и осознанное отношение к здоровью – все здесь.
Растущее число бактериальных заболеваний в России требует активного вмешательства государства! Узнайте, как формируется политика борьбы с инфекциями и какие меры принимаются.
Узнайте, как генетика влияет на развитие бактериальных инфекций и почему антибиотики теряют свою эффективность. Разбираемся в проблеме устойчивости и современных методах борьбы!
Пятна на листьях? Не паникуйте! Узнайте, как распознать и вылечить бактериальные инфекции у комнатных растений. Советы по реабилитации и профилактике!
Узнайте, как бактериальные инфекции могут вызывать тревогу, депрессию и когнитивные нарушения. Связь тела и разума – что нужно знать о влиянии бактерий на психическое здоровье!
Ваши комнатные растения болеют? Узнайте, как распознать и предотвратить бактериальные инфекции! Советы по уходу и защите вашего зеленого уголка. Бактериальные инфекции - больше не проблема!
Узнайте, как пробиотики и пребиотики восстанавливают микрофлору кишечника после инфекций, улучшают пищеварение, укрепляют иммунитет и влияют на ваше самочувствие!
Беспокоитесь о здоровье во время беременности? Узнайте о распространенных бактериальных инфекциях, их влиянии на маму и малыша, а также способах защиты и диагностики.
Заразились бактериальной инфекцией? Узнайте о ваших правах, компенсациях и юридической защите в России. Подробно о последствиях и способах решения проблем!
Узнайте, как предотвратить послеоперационные инфекции! Подробные советы и рекомендации для быстрого и безопасного восстановления после операции. Защитите себя!